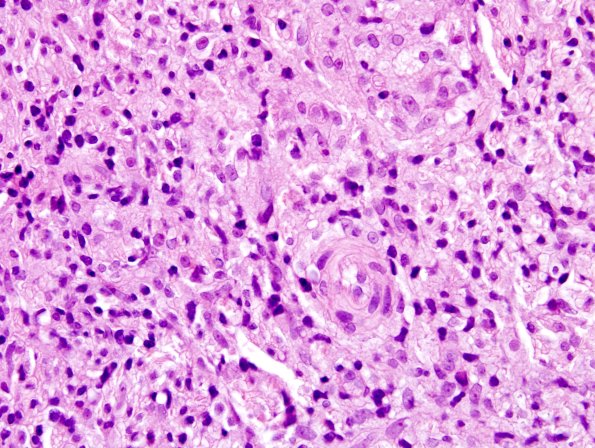
2A7 Leprosy, tuberculoid (Case 2) H&E 1A

Table of Contents
Washington University Experience | PERIPHERAL NEUROPATHY | 10 INFECTION | 4 Leprosy – Tuberculoid | 2A7 Leprosy, tuberculoid (Case 2) H&E 1A
Higher magnification images of one fascicle showing the epithelioid histiocytes at multiple magnifications. (H&E)